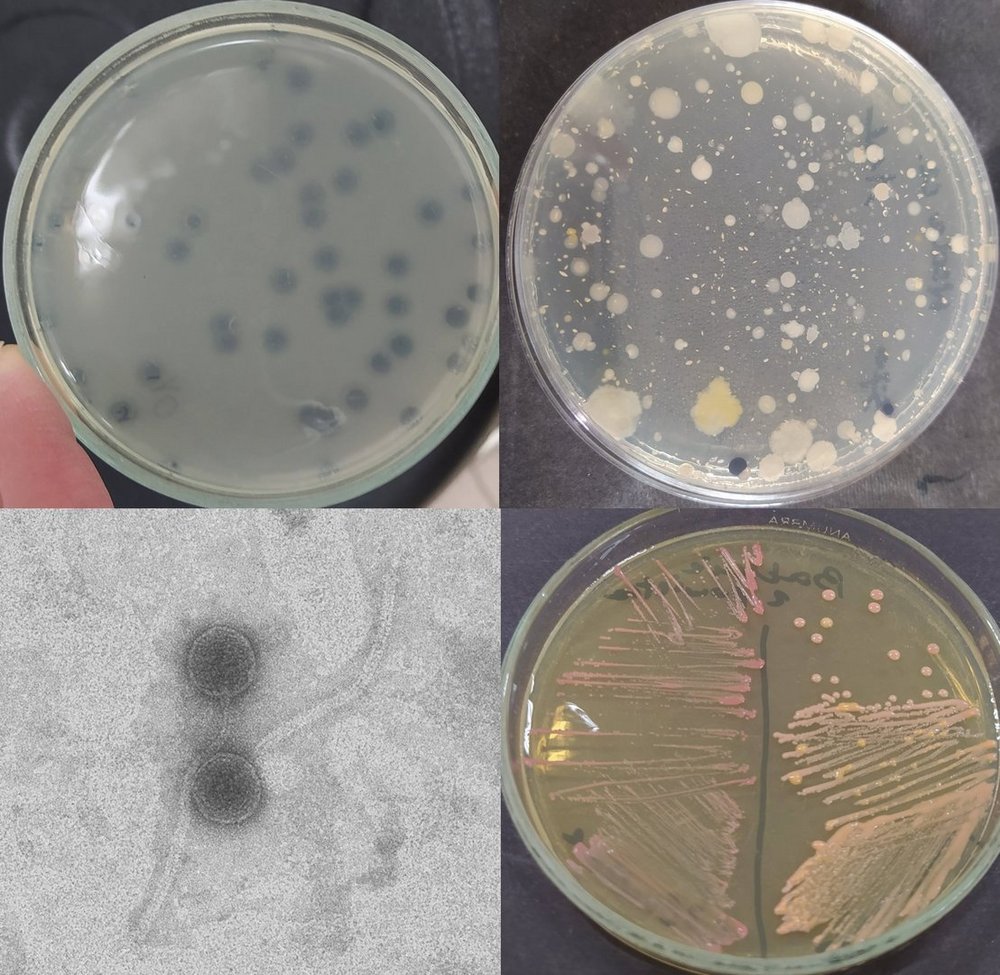
rózne próbki

Projekt „CityBiome – odkrywając miejski mikrobiom Łodzi – w kierunku środowiska bezpiecznego i przyjaznego mieszkańcom”
Celem projektu realizowanego przed badaczy i studentów Uniwersytetu Łódzkiego oraz Uniwersytetu w Zagrzebiu jest poznanie mikrobiomu miejskiego oraz identyfikacja bakteriofagów zdolnych do zwalczania opornych na antybiotyki bakterii bytujących w środowisku. Badania będą realizowane poprzez pobór próbek ścieków i wód opadowych, izolację bakterii i bakteriofagów oraz analizę aktywności tych wirusów wobec wybranych szczepów bakteryjnych. Spodziewane rezultaty to uzyskanie kolekcji szczepów bakterii i fagów, przygotowanie podstaw do praktycznego wykorzystania wyników badań w oczyszczaniu ścieków oraz rozwój współpracy naukowej i umiejętności badawczych studentów.
Partnerem projektu jest Wydział Kształtowania Środowiska UMŁ , którego profil działalności obejmuje działania związane z ochroną i kształtowaniem środowiska w Łodzi, w tym zarządzanie gospodarką odpadami, ochronę zieleni miejskiej, prowadzenie nadzoru nad jakością powietrza oraz realizację polityki ekologicznej miasta. Wydział udostępni lokacje do pobierania próbek, weźmie udział w analizie wyników badań i wesprze zespół w interpretacji danych w kontekście potrzeb miasta. Dzięki Wydziałowi Kształtowania Środowiska wyniki projektu będą mogły być wykorzystane do tworzenia polityk miejskich i regulacji środowiskowych.
Projekt dostarczy wiedzy o obecności w miejskich ściekach bakteriofagów, które mogą ograniczać rozwój bakterii chorobotwórczych. Wyniki badań mogą pomóc Wydziałowi Kształtowania Środowiska UMŁ lepiej oceniać stan środowiska i planować działania na rzecz poprawy jakości wód oraz bezpieczeństwa sanitarnego w mieście. Dla Łodzi projekt ma znaczenie praktyczne – może przyczynić się do wdrażania nowoczesnych, biologicznych metod wspierających proces oczyszczania ścieków.
Zespół projektowy
- Dr Magdalena Moryl – adiunkt w Katedrze Biologii Bakterii na Wydziale Biologii i Ochrony Środowiska Uniwersytetu Łódzkiego. Zajmuje się badaniami nad biofilmamibakteryjnymi tworzonymi przez bakterie uropatogenne, oraz oceną potencjału bakteriofagów w zwalczaniu drobnoustrojów opornych na antybiotyki. Praca: The Combination of Phage Therapy and β-Lactam Antibiotics for the Effective Treatment of Enterococcus faecalis Infections, DOI: 10.3390/ijms26010011. Int. J Mol. Sci 2025
- Prof. Jasna Hrenović - nauczyciel akademicki Uniwersytetu w Zagrzebiu Wydział Nauk Ścisłych, Instytut Biologii. Obszary zainteresowań badawczych prof. Hrenovićobejmują oczyszczanie ścieków, media wodne oraz bakteriologię.
- Weronika Morgaś – studentka II r. Mikrobiologia, mikrobiologia medyczna, immunologia i diagnostyka laboratoryjna, stacjonarne 2-go stopnia. Praca dyplomowa: Fagi umiarkowane jako źródło zmienności bakterii
- Mgr Blanca Dadic - studentka odbywającą studia doktoranckie na Uniwersytecie w Zagrzebiu, na Wydziale Biologii. Praca: Carbapenem-resistant bacteria in the environment, https://doi.org/10.2478/aiht-2025-76-3956, Archives of Industrial Hygiene and Toxicology, 2025
- Anna Wierzbicka - Dyrektor Wydziału Kształtowania Środowiska UMŁ
Science Hub UniLodz (SH) to platforma współpracy Uniwersytetu Łódzkiego, która łączy osoby studiujące, uczelnianych ekspertów i ekspertki oraz podmioty zewnętrzne, wspierając ich w realizacji innowacyjnych projektów naukowych i wdrożeniowych. Zespoły działające w ramach SH wspólnie podejmują się rozwiązywania realnych wyzwań naukowych zgłaszanych przez organizacje partnerskie.
Projekt „We are UNIC!” jest finansowany ze środków Unii Europejskiej w ramach programu „Support for European University Alliances”, projekt NAWA FERS.01.05-IP.08-0219/23, kwota: 62,705,297.60 zł.